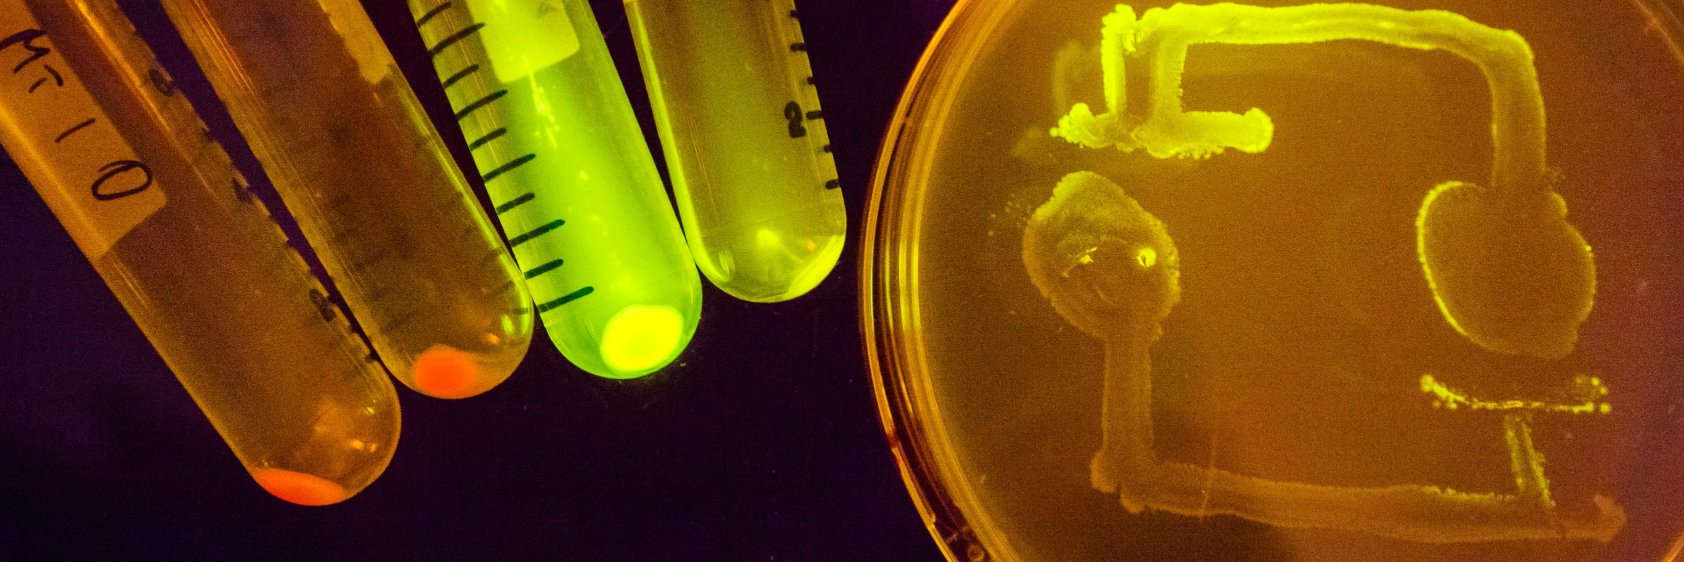
Imperial College Centre for Synthetic Biology banner

Imperial College Centre for Synthetic Biology retweetledi

Very happy that Javi and Rakesh's paper has finally come out in @NatureChemistry (link in reply). We use DNA nanotechnology to implement a synthetic molecular templating system - a minimal analog of the processes that are crucial to assembling complex proteins in the cell.
English